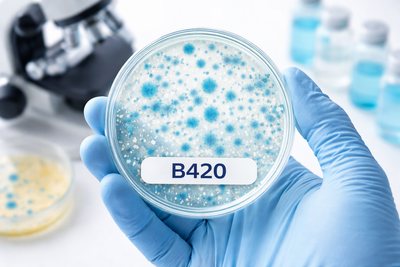
The B420 Strain: Why This Probiotic Matters for Weight Management

Microbiome Weight Management Therapy: A Science-Backed Approach to Sustainable Weight Loss

Losing weight and keeping it off has never been just about willpower. If you've struggled with stubborn belly fat, constant cravings, or weight that creeps back no matter what you try, the answer might not be another restrictive diet. It might be in your gut.
WonderBiotics Microbiome Weight Management Therapy is a clinically studied probiotic formula designed to address weight management at its source: your gut microbiome. This isn't about quick fixes or empty promises. It's about retraining your body's metabolic system for long-term, sustainable results.
What Makes Microbiome Weight Management Therapy Different?
Not all probiotics are created equal, and most weren't designed with weight management in mind. WonderBiotics Microbiome Weight Management Therapy stands apart because every ingredient was chosen based on rigorous clinical research involving 44,692 human subjects across hundreds of studie.
Why this matters: When you see "probiotics" on a label, you're often getting generic bacterial strains with no proven track record for weight management. WonderBiotics uses precision-ID strains that are DNA-verified and traceable, meaning you're getting the exact bacteria that worked in clinical trials, not random substitutes.
The MetaboPilot™ and CraveLock™ Advantage
This formula combines two proprietary blends designed to work together:
MetaboPilot™ focuses on metabolic health. It targets how your body processes glucose, burns fat, and maintains energy balance. The star player here is Bifidobacterium animalis subsp. lactis B420, a strain backed by 30 clinical studies and trusted by 252 doctors for weight management support.
CraveLock™ addresses appetite regulation. It includes dihydroberberine (5X more bioavailable than regular berberine) and lemon fruit extract standardized to 70% eriocitrin, which together support healthy GLP-1 levels to naturally balance hunger and metabolism.
Why you should care: Your gut bacteria literally communicate with your brain about hunger, fullness, and cravings. If your microbiome is out of balance, you're fighting an uphill battle against your own biology. This formula helps reset that communication.
The Clinical Evidence Behind the Formula
B420: The Belly Fat Fighter
In a 6-month randomized, double-blind, placebo-controlled trial with 225 participants, those taking B420 experienced:
- 0.94-inch reduction in waist circumference (that's about one full clothing size)
- 320-calorie reduction in daily energy intake without feeling deprived
- Significant reduction in body fat mass, particularly around the midsection
Why this matters: That 320-calorie reduction per day adds up to roughly 2,240 calories per week. Over the course of a month, that's nearly 10,000 fewer calories consumed naturally, without white-knuckling through hunger. And importantly, 80% of participants in the key clinical study were women aged 45-60, making this particularly relevant for managing menopause-related weight gain.
Check out our B420 Evidence Card for more Information
HN019: The Digestive Support System
Bifidobacterium animalis subsp. lactis HN019 has been studied by Mayo Clinic researchers and shows powerful benefits for gut health:
- Reduced whole gut transit time from 49 hours to 21 hours in just 14 days
- Significant reduction in bloating, gas, and constipation
- Improved regularity and digestive comfort
Why this matters: If you're taking GLP-1 medications like Ozempic, Wegovy, or Mounjaro, you know the digestive side effects can be brutal. HN019 helps relieve nausea, bloating, and GI discomfort within 14 days, making it an ideal companion to these medications.
Check out our HN019 Evidence Card for more Information
Dihydroberberine: Blood Sugar Support
Regular berberine has been used for centuries, but it has one major problem: poor absorption. Your body breaks down most of it before it can do any good.
Dihydroberberine solves this problem. It's 5 times more bioavailable than regular berberine, which means you get superior support for:
- Blood sugar regulation
- Insulin sensitivity
- Metabolic flexibility
Why this matters: Stable blood sugar means fewer energy crashes, reduced cravings, and better fat burning throughout the day. When your blood sugar is constantly spiking and crashing, your body stores more fat and burns less.
Lemon Fruit Extract: The GLP-1 Booster
Standardized to 70% eriocitrin, this extract promotes healthy GLP-1 levels naturally. GLP-1 is the same hormone that weight loss medications like Ozempic mimic, but this approach supports your body's own production.
Why this matters: Natural GLP-1 support means better appetite control and improved metabolic signaling without the side effects of pharmaceutical interventions.
The Supporting Cast: Beneficial Bacteria Profile
Beyond the star ingredients, this formula includes powerhouse probiotic strains with extensive research backing:
- Lactobacillus acidophilus NCFM: 105 studies, 9,533 subjects. Supports digestive comfort and regularity.
- Lacticaseibacillus rhamnosus GG: 294 studies, 11,457 subjects. One of the most studied probiotics in the world.
- Additional strains: Ls-33, Ll-23, Lpc-37, and Lp-116, each with their own clinical evidence for gut health support.
Why this matters: A diverse microbiome is a healthy microbiome. These strains work together to create a balanced gut ecosystem that supports not just weight management, but overall digestive wellness.
Why This Product Actually Survives to Your Gut
Here's a dirty secret about the probiotic industry: most products don't deliver what's on the label by the time you take them, and even fewer survive the harsh journey through your stomach acid.
WonderBiotics uses advanced freeze-drying technology to lock in potency. This process:
- Preserves live bacteria for up to 2 years after manufacturing
- Ensures above 96% survival through stomach acid and bile
- Guarantees 20 billion CFU at the time you actually take it, not just when it was bottled
Why this matters: You could buy a probiotic with "50 billion CFU" on the label, but if most of them are dead before they reach your gut, you're wasting your money. Freeze-dried probiotics maintain their potency and effectiveness long after cheaper formulations have degraded.
The exclusive packaging blocks light, water, and oxygen with a premium aluminum seal, keeping the strains active and effective right up until they reach your intestines where they can actually do their job.
What to Expect: A Realistic Timeline
Microbiome Weight Management Therapy works progressively, building sustainable changes rather than delivering overnight miracles.
Day 7: Digestive Comfort You'll likely notice less bloating and gas as your gut bacteria start to rebalance. Some people experience mild initial bloating as their microbiome adjusts, especially if they've been eating a low-fiber diet, but this typically resolves within 1-2 weeks.
Day 14: Healthy Metabolism You should start feeling lighter and more vibrant throughout the day. Energy levels often improve as gut function optimizes.
Month 1: Stable Blood Sugar Fewer cravings and more sustained energy. Many people report that their usual 3 PM energy crash disappears, and nighttime snacking becomes easier to resist.
Month 3: Waistline Reduction This is when the clinical evidence really shows up. The 0.94-inch waist reduction observed in studies typically becomes noticeable around this point. That's equivalent to dropping 5-10 pounds or going down a full clothing size.
Month 6: Leaner Body Composition Your metabolic system has been refreshed by your newly populated gut microbiome. You've activated what we call an "easy-slim body type," where maintaining a healthy weight becomes easier because your biology is working with you, not against you.
Who This Product Is For (And Who It's Not For)
Microbiome Weight Management Therapy is ideal for:
- Women 45-60 experiencing menopause-related weight gain, particularly stubborn belly fat
- People on GLP-1 medications (Ozempic, Wegovy, Mounjaro) who need digestive support
- Anyone struggling with appetite control and cravings despite healthy eating efforts
- Individuals looking for hormone-free, stimulant-free weight management support
- Those committed to 3-6 months of consistent use alongside healthy lifestyle habits
This product is NOT for:
- People expecting overnight results or 10-pound weight loss in a week
- Pregnant or nursing mothers, as pregnancy requires healthy fat stores
- Anyone looking for a replacement for diet and exercise rather than a supportive tool
- Those not willing to commit to at least 3 months of daily use
How to Use It for Best Results
Take one capsule daily, ideally within 30 minutes after a meal. This timing helps the probiotics survive stomach acid more effectively since food buffers the pH.
Commit to at least 3 months, ideally 6 months or longer. Your gut microbiome doesn't shift overnight. You're building a new metabolic baseline, not doing a quick detox.
Pair it with lifestyle fundamentals:
- Stop eating 3 hours before sleep to maximize overnight fat burning
- Get 7-9 hours of quality sleep to regulate hunger hormones
- Eat in this order: fiber → protein → carbs to feel full sooner and stabilize blood sugar
Why consistency matters: Think of this like building muscle at the gym. Going once won't do much. Going consistently for months rewires your body. The same principle applies to rebuilding your gut microbiome.
The Bottom Line
Microbiome Weight Management Therapy isn't magic, and it won't do the work for you. But if you're tired of fighting your own body, if you're frustrated by weight that keeps coming back, or if you're looking for science-backed support that addresses root causes rather than symptoms, this formula offers a real solution.
With 624 clinical studies backing its key ingredients, 44,692 human subjects providing real-world evidence, and advanced manufacturing that ensures what's on the label is what reaches your gut, this represents the cutting edge of microbiome-based weight management.
Ready to activate your easy-slim body type? Learn more about WonderBiotics Microbiome Weight Management Therapy.
References
- Stenman LK, et al. Probiotic with or without fiber controls body fat mass, associated with serum zonulin, in overweight and obese adults: randomized controlled trial. EBioMedicine. 2016;13:190-200. https://pubmed.ncbi.nlm.nih.gov/27810310/
- Waller PA, et al. Dose-response effect of Bifidobacterium lactis HN019 on whole gut transit time and functional gastrointestinal symptoms in adults. Scand J Gastroenterol. 2011;46(9):1057-1064. https://pubmed.ncbi.nlm.nih.gov/21663486/
- Turner N, et al. Berberine and its more biologically available derivative, dihydroberberine, inhibit mitochondrial respiratory complex I. Diabetes. 2008;57(5):1414-1418. https://pmc.ncbi.nlm.nih.gov/articles/PMC8746601/

Taylor Cottle, PhD
Biotechnologist | PhD from Johns Hopkins
Read more

The WonderBiotics Philosophy: Why We Do What We Do and How We Think About Gut Health

Clean Nutraceuticals: An Evidence-Based Guide to Choosing High-Quality Supplements That Actually Work

WonderBiotics BlueBook: Weight Management Compendium (2026 Edition)